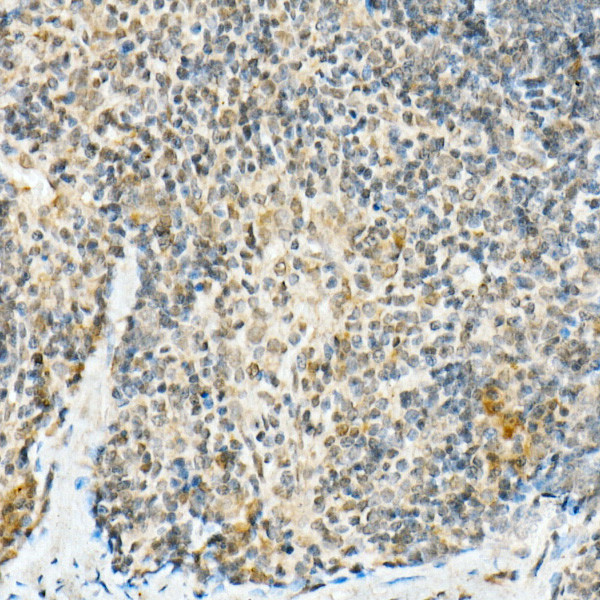
FADD Antibody in Immunohistochemistry (Paraffin) (IHC (P))

Search
Invitrogen
FADD Recombinant Rabbit Monoclonal Antibody (10L6M0)
{{$productOrderCtrl.translations['antibody.pdp.commerceCard.promotion.promotions']}}
{{$productOrderCtrl.translations['antibody.pdp.commerceCard.promotion.viewpromo']}}
{{$productOrderCtrl.translations['antibody.pdp.commerceCard.promotion.promocode']}}: {{promo.promoCode}} {{promo.promoTitle}} {{promo.promoDescription}}. {{$productOrderCtrl.translations['antibody.pdp.commerceCard.promotion.learnmore']}}
图: 1 / 6
FADD Antibody (MA5-38032) in IHC (P)






Please note: We are reviewing Western blot images included in the antibody testing data in our catalog, including those provided by third parties. Unless expressly labeled or annotated as “raw-unedited”, Western blot images included in the antibody testing data in our catalog may have been edited, optimized or otherwise adjusted for presentation.
产品信息
MA5-38032
种属反应
宿主/亚型
Expression System
分类
类型
克隆号
抗原
偶联物
形式
浓度
规格
纯化类型
保存液
内含物
保存条件
运输条件
RRID
产品详细信息
Positive Samples: NIH/3T3, Mouse brain, Mouse thymus
Immunogen sequence: MDPFLVLLHS LSGSLSGNDL MELKFLCRER VSKRKLERVQ SGLDLFTVLL EQNDLERGHT GLLRELLASL RRHDLLQRLD DFEAGTATAA PPGEADLQVA FDIVCDNVGR DWKRLARELK VSEAKMDGIE EKYPRSLSER VRESLKVWKN AEKKNASVAG LVKALRTCRL NLVADLVEEA QESVSKSENM SPVLRDSTVS SSETP
靶标信息
The protein encoded by this gene is an adaptor molecule that interacts with various cell surface receptors and mediates cell apoptotic signals. Through its C-terminal death domain, this protein can be recruited by TNFRSF6/Fas-receptor, tumor necrosis factor receptor, TNFRSF25, and TNFSF10/TRAIL-receptor, and thus it participates in the death signaling initiated by these receptors. Interaction of this protein with the receptors unmasks the N-terminal effector domain of this protein, which allows it to recruit caspase-8, and thereby activate the cysteine protease cascade. Knockout studies in mice also suggest the importance of this protein in early T cell development.
仅用于科研。不用于诊断过程。未经明确授权不得转售。
篇参考文献 (0)
生物信息学
蛋白别名: FAS-associated death domain protein; FAS-associating death domain-containing protein; Fas-associating protein with death domain; Growth-inhibiting gene 3 protein; Mediator of receptor induced toxicity; MGC8528; protein FADD
基因别名: FADD; GIG3; MORT1; Mort1/FADD
UniProt ID: (Mouse) Q61160
Entrez Gene ID: (Mouse) 14082, (Rat) 266610